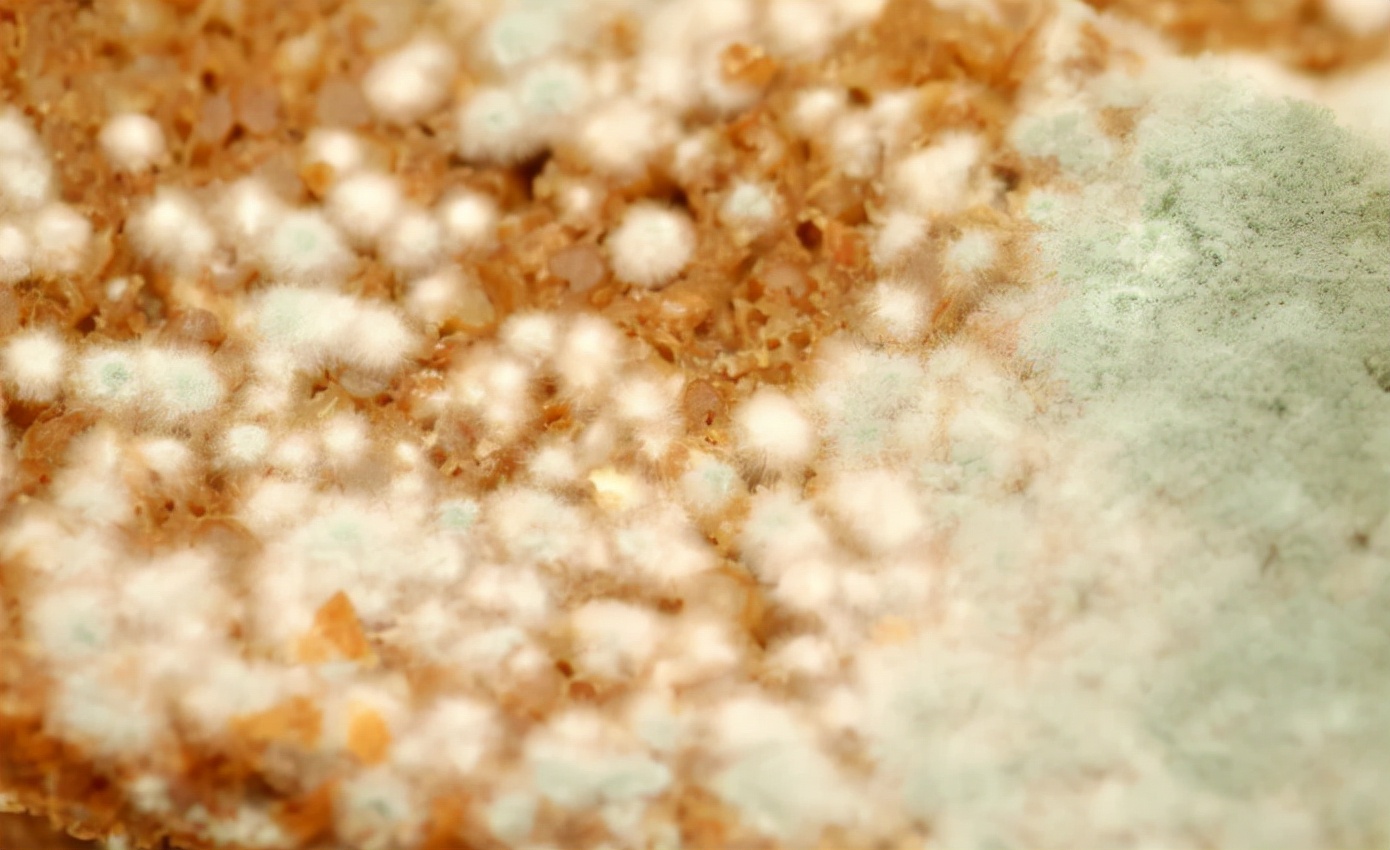
|多所医院联合呼吁：停止使用“1电饭煲”，或是肝癌“催化剂”

|多所医院联合呼吁:停止使用“1电饭煲”,或是肝癌“催化剂”

文章图片

文章图片
文章图片

小龙和羊羊大学毕业后就结婚了 , 至今已经是第五个年头了 。 小两口在小龙公司附近租了个一居室 , 方便上下班 。 夫妻二人都来自农村 , 好不容易走出家门 , 为了能买房子 , 在城里落脚 , 两人工作都很努力 , 平日生活也较节俭 。
然而最近一段时间 , 羊羊总是感到头晕恶心 , 食欲也下降了很多 , 闻到油腻的味道就感到反胃 , 要不是生理期刚过 , 她一度以为自己怀孕了 。
然而更加糟糕的是 , 没过两天 , 小龙也出现了相同的症状 。 这可把两人吓坏了 , 也不再害怕花钱了 , 赶紧去医院进行检查 。
检查结果仿佛晴天霹雳 , 医生告诉夫妻二人都被检查出来了肝癌 。 听到这个消息 , 二人面面相觑 , 震惊的说不出话来 。
医生随后与他俩详细的沟通后 , 指出了原因 。
多所医院联合呼吁:停止使用这“1电饭煲” , 或是肝癌“催化剂”
原来 , 小两口刚搬到出租房 , 在添置锅碗瓢盆等生活用品时 , 刚好赶上商家做活动 , 送了一个电饭煲当礼品 。 这还真是瞌睡就有人递枕头 , 即使质量差点 , 也总比再花钱买好 , 就使用了起来 。
这一用就是五年 , 可他们不知道的是 , 自己用的电饭煲 , 内胆是铝制涂层的 , 没有保护外层 。 这种电饭煲内胆容易与自来水中消毒的氟化物发生反应 , 从而使铝离子溶解并进入食物中 。
长时间下来 , 对肝脏健康十分不利 , 不但会引发肝细胞受损 , 还会使患上肝癌的风险大大提高 。
除此之外 , 生活中频繁食用这2食物 , 或也会诱发肝脏疾病
1、腌菜
腌菜不但方便储存 , 而且风味独特 , 受到大众的喜爱 。
市面上的很多腌菜颜色艳丽 , 勾人食欲 , 这其实是添加了染色剂 , 吃多了会增加甘昂工作负担 , 非常不利于肝脏健康 。
此外腌菜中含有大量的盐分 , 发酵制作过程中很容易滋生亚硝酸盐 。 进入体内后会形成亚硝胺致癌物 。 摄取过多 , 不但会引起肝部组织硬化 , 严重甚至产生癌变 , 危害生命健康 。
2、隔夜饭菜
饭菜放置时间过长 , 容易滋生各种细菌 , 其中的黄曲霉毒素对肝脏的毒性十分大 , 微量摄入就会引发呕吐、恶心等不适症状 , 长期食用 , 更会降低肝部的免疫力 。 久而久之 , 使肝细胞出现坏死和病变 , 导致肝硬化 , 甚至肝癌的发生 。
医生:坚持这件事 , 肝病见你或绕着走
参考资料:
【|多所医院联合呼吁:停止使用“1电饭煲”,或是肝癌“催化剂”】【1】肝病患者常见的十大症状 , 健康医学 , 2019.10.12
- 射线|北京北城甲状腺医院提醒:甲状腺疾病高发要如何预防?这5件事要做好
- 脏腑|重庆肿瘤专科医院:中医帮你调和气血,平衡阴阳
- 心脑血管|大荔中医医院脾胃肺病科“妙手回春”受到患者的称赞
- 需求|预约诊疗 | 齐齐哈尔市中医医院1月17日—1月23日医生出诊一览表
- 变化|邵东市中医医院:血压很“善变” 怎么办?
- 疾病|永州中心医院消化科成功开展内镜下内痔套扎术
- 解读|《浙江省医院门诊管理办法》政策解读
- 中藏医院|四川省骨科医院与松潘县中藏医院专科联盟
- 脊柱|邵阳学院附属第一医院脊柱骨病科、康复科携手让26岁瘫痪小伙再行走
- 领导|邵阳召开强化新冠肺炎定点救治医院管理工作视频会议
